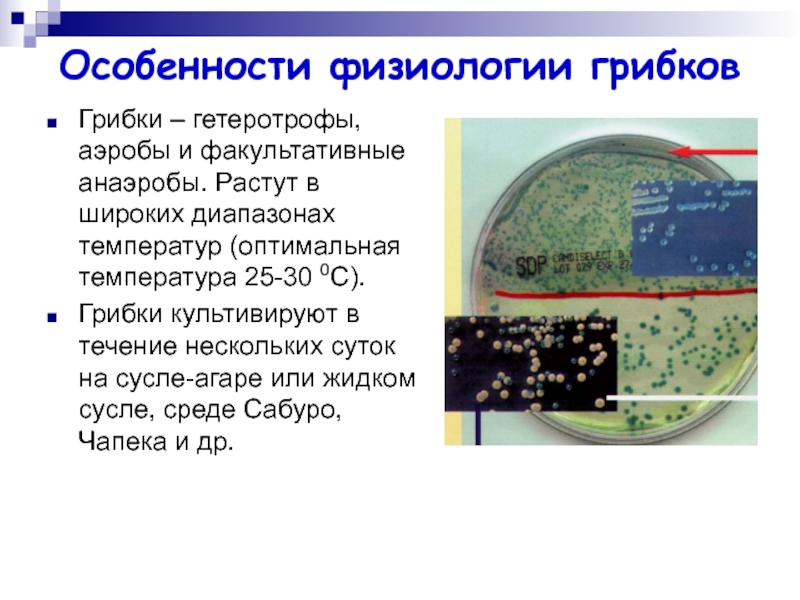
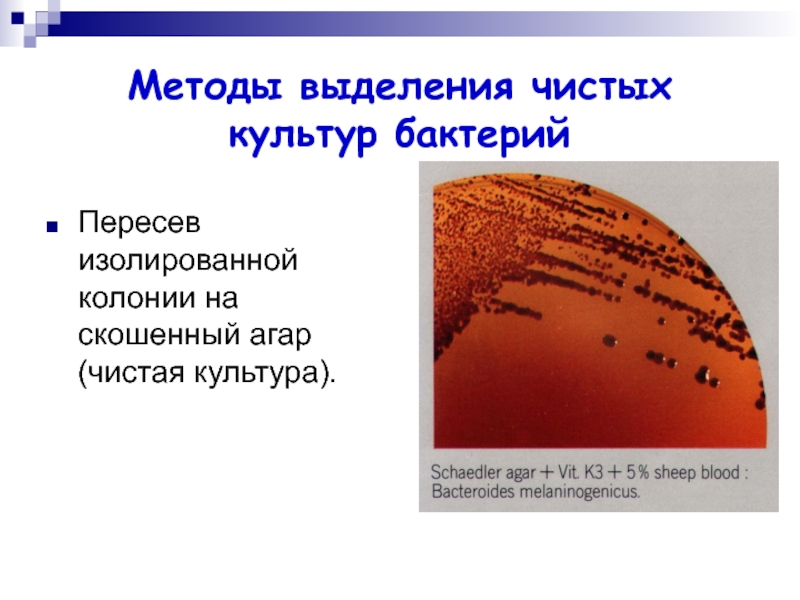

Разделы презентаций
- Разное
- Английский язык
- Астрономия
- Алгебра
- Биология
- География
- Геометрия
- Детские презентации
- Информатика
- История
- Литература
- Математика
- Медицина
- Менеджмент
- Музыка
- МХК
- Немецкий язык
- ОБЖ
- Обществознание
- Окружающий мир
- Педагогика
- Русский язык
- Технология
- Физика
- Философия
- Химия
- Шаблоны, картинки для презентаций
- Экология
- Экономика
- Юриспруденция
ФИЗИОЛОГИЯ БАКТЕРИЙ
Содержание
- 1. ФИЗИОЛОГИЯ БАКТЕРИЙ
- 2. Половое размножение грибковПоловые споры возникают в результате
- 3. Споры грибковЭндоспоры. Mucor mucedo: спорофора представляет собой
- 4. Спорофоры грибков
- 5. Размножение грибковДрожжи – почкование. Путем разлома гиф
- 6. Таксономическое положениеЦарство – Грибки (Mycota или Fungi)Отделы
- 7. Методы выявленияГрибки выявляют в окрашенных по Граму, Романовскому-Гимзе, Цилю-Нильсену препаратах.В нативных неокрашенных препаратах.
- 8. ФИЗИОЛОГИЯ БАКТЕРИЙМ.Р. Карпова
- 9. Физиология микроорганизмов – раздел микробиологии, изучающий жизнедеятельность
- 10. Значение физиологии микроорганизмовФизиологические и биохимические особенности микроорганизмов
- 11. Химический состав микроорганизмоввода (до 80% массы),белки, нуклеиновые
- 12. Классификация микроорганизмов по типу питания
- 13. Механизмы проникновения питательных веществ в бактериальную клеткуПассивная
- 14. Пути выхода соединений из бактериальной клеткиФосфотрансферазная реакция.
- 15. Дыхание бактерий Аэробное дыхание: акцептором водорода или
- 16. По отношению к молекулярному кислородуОблигатные аэробы. Микроаэрофилы
- 17. Размножение бактерийБактерии размножаются бинарным делением, реже почкованием,
- 18. Фазы размножения бактерий
- 19. Классификация питательных сред по природе – естественные
- 20. Условия культивированияРазличные группы микроорганизмов размножаются при определенных
- 21. Условия культивированиярН – большинство растет при рН
- 22. Методы промышленного культивирования бактерий Биореакторы (ферментеры). В
- 23. Особенности культивирования риккетсий и хламидийРиккетсии и хламидии
- 24. Особенности культивирования микоплазмФакультативные анаэробы. В питательные среды
- 25. Особенности культивирования спирохетСпирохеты хемоорганотрофы, среди них есть
- 26. Особенности физиологии грибковГрибки – гетеротрофы, аэробы и
- 27. Особенности физиологии простейшихПростейшие по типу питания могут
- 28. Ферменты микроорганизмов оксидоредуктазы – окислительно-восстановительные ферменты (к
- 29. Ферменты микроорганизмовЭндоферменты и экзоферменты. Внутриклеточные ферменты, объединенные
- 30. Методы выделения чистых культур бактерий Посев в
- 31. Методы выделения чистых культур бактерийПересев изолированной колонии на скошенный агар (чистая культура).
- 32. Методы выделения чистых культур бактерийИзучение морфологических, тинкториальных,
- 33. Скачать презентанцию
Половое размножение грибковПоловые споры возникают в результате слияния двух ядер, содержащих по гаплоидному набору хромосом (слияние гамет). Слившиеся гаметы формируют диплоид, который затем подвергается редукционному делению (мейоз) с последующим образованием гаплоидных
Слайды и текст этой презентации
Слайд 1Размножение грибков
Различают два способа размножения грибов: половое и бесполое. Большинство
грибков способны размножаться обоими способами.
Слайд 2Половое размножение грибков
Половые споры возникают в результате слияния двух ядер,
содержащих по гаплоидному набору хромосом (слияние гамет). Слившиеся гаметы формируют
диплоид, который затем подвергается редукционному делению (мейоз) с последующим образованием гаплоидных клеток-спор.Возникающие половые органы у низших грибков называют ооспорами и зигоспорами, у высших грибков — аскоспорами и базидиоспорами.
Слайд 3Споры грибков
Эндоспоры. Mucor mucedo: спорофора представляет собой спорангиеносец, на терминальном
конце которого находится закрытое вместилище — спорангий, содержащий спорангиоспоры.
Экзоспоры,
или конидии, спорофоры — конидиофоры, или конидиеносцы.Слайд 5Размножение грибков
Дрожжи – почкование.
Путем разлома гиф на отдельные клетки
– оидии или артроспоры.
Клетки окруженные толстой стенкой – хламидиоспоры.
Некоторые дрожжи размножаются делением пополам.
Слайд 6Таксономическое положение
Царство – Грибки (Mycota или Fungi)
Отделы – Грибки слизевики
(Myxomycota) и настоящие грибки (Eumycota)
Отдел Eumycota подразделяют на семь классов:
∙ Basidiomycetes (шляпочные грибы).
∙ Zygomycetes (включают род Mucor, способен вызывать мукоромикоз человека и животных).
∙ Ascomycetes (или сумчатые грибки, относятся к высшим грибкам, к ним относятся роды Aspergillus, Penicillium, а также дрожжевые грибки).
∙ Deuteromycetes – несовершенные грибки, не размножаются половым путем (Candida).
Слайд 7Методы выявления
Грибки выявляют в окрашенных по Граму, Романовскому-Гимзе, Цилю-Нильсену препаратах.
В
нативных неокрашенных препаратах.
Слайд 9Физиология микроорганизмов – раздел микробиологии, изучающий жизнедеятельность микробов, процессы их
питания, обмена, дыхания, роста, размножения, закономерности взаимодействия с окружающей средой.
Обеспечение
жизненных
функцийСлайд 10Значение физиологии микроорганизмов
Физиологические и биохимические особенности микроорганизмов положены в основу
их систематики.
Важны для изучения механизмов патогенного действия, культивирования, дифференцировки и
идентификации отдельных микроорганизмов.Для разработки биотехнологии производства вакцин, антибиотиков и других биологически активных продуктов.
Для понимания патогенеза, постановки микробиологического диагноза, проведения лечения и профилактики инфекционных заболеваний, регуляции взаимоотношений человека с окружающей средой и т.д.
Слайд 11Химический состав микроорганизмов
вода (до 80% массы),
белки,
нуклеиновые кислоты,
углеводы,
липиды,
минеральные вещества (цинк, медь, кобальт, барий, марганец и др.).
Слайд 13Механизмы проникновения питательных веществ в бактериальную клетку
Пассивная диффузия: перемещение веществ
происходит по градиенту концентрации, без затраты энергии (органические молекулы, лекарственные
препараты, H2O, O2, CO2, N2).Облегченная диффузия происходит также по градиенту концентрации, без затраты энергии. С помощью молекул-переносчиков, пермеаз.
Активный транспорт происходит с затратой метаболической энергии – АТФ.
Транслокация (перенос) групп
является активным транспортом при
участии мембранных белков-
транслоказ и фосфорилировании
переносимой молекулы в процессе
ее прохождения через мембрану
(глюкоза).
Слайд 14Пути выхода соединений из бактериальной клетки
Фосфотрансферазная реакция. Происходит при фосфорилировании
переносимой молекулы.
Контрансляционная секреция. Синтезируемые молекулы должны иметь особую лидирующую последовательность
аминокислот, чтобы прикрепиться к мембране и сформировать канал, через который молекулы белка смогут выйти в окружающую среду. Токсины столбняка, дифтерии и другие молекулы.Почкование мембраны. Молекулы, образующиеся в клетке, окружаются мембранным пузырьком, который отшнуровывается в окружающую среду.
Слайд 15Дыхание бактерий
Аэробное дыхание: акцептором водорода или электронов служит молекулярный
кислород.
Анаэробное: акцептором служат нитрат, сульфат, фумарат.
Брожение: донорами и акцепторами
водорода являются органические соединения. По конечному продукту расщепления углеводов различают спиртовое, молочнокислое, уксуснокислое и другие виды брожения.Слайд 16По отношению к молекулярному кислороду
Облигатные аэробы.
Микроаэрофилы – от 0,01
до 0,03 бар парциального давления кислорода (в воздухе 0,20 бар).
Облигатные анаэробы (клостридии ботулизма, газовой гангрены, столбняка, бактероиды и др.) растут на среде без кислорода, не образуют каталазу, пероксидазу и супероксиддисмутазу.
Факультативные анаэробы способны переключаться с дыхания в присутствии молекулярного кислорода на брожение в отсутствие молекулярного кислорода (Enterobacteriaceae).
Аэротолерантные бактерии (молочнокислые бактерии).
Слайд 17Размножение бактерий
Бактерии размножаются бинарным делением, реже почкованием, актиномицеты – спорами
и фрагментацией.
Грамотрицательные бактерии делятся путем перетяжки.
Грамположительные бактерии делятся
путем врастания синтезирующихся перегородок деления внутрь клетки. Слайд 19Классификация питательных сред
по природе – естественные и искусственные питательные
среды;
по консистенции – плотные, полужидкие и жидкие;
по составу –
простые, сложные;по назначению – специальные, элективные и дифференциально-диагностические.
Слайд 20Условия культивирования
Различные группы микроорганизмов размножаются при определенных диапазонах температур. Бактерии,
растущие при низких температурах, называются психофилами, при средних (около 370С)
– мезофилами, при высоких – термофилами.Слайд 21Условия культивирования
рН – большинство растет при рН 7, многие бактерии
растут в пределах от 6 до 9.
Относительная влажность. Микроорганизмы
способны расти при относительной влажности от 0,998 до 0,6. Для большинства – превышает 0,98.Для облигатных аэробов в необходим молекулярный кислород. Увеличение поверхности раздела:
1) культивирование в тонком слое;
2) перемешивание жидкости путем встряхивания;
3) вращение лежащих сосудов вокруг продольной оси;
4) пропускание воздуха через жидкость под давлением и др.
При выращивании строго анаэробных культур бактерий необходимо исключить доступ кислорода.
Слайд 22Методы промышленного культивирования бактерий
Биореакторы (ферментеры).
В качестве питательных сред
используют дешевое, сырье (рыбно-костную муку, отходы сахарного производства, дрожжевой экстракт).
Из
1 т культуры за это время получается примерно 50 кг биомассы. Высокопродуктивные промышленные штаммы микроорганизмов.
Из культуральной жидкости выделяют и концентрируют биомассу бактерий с помощью различных методов (сепарирование, центрифугирование, седиментация, выпаривание, ультрафильтрация, хроматография).
Слайд 23Особенности культивирования риккетсий и хламидий
Риккетсии и хламидии – облигатные внутриклеточные
паразиты.
Для их культивирования применяют куриные эмбрионы, культуры клеток и чувствительных
животных. Риккетсии можно культивировать путем инфицирования ими переносчиков возбудителя инфекций – вшей, блох, клещей.
Слайд 24Особенности культивирования микоплазм
Факультативные анаэробы.
В питательные среды добавляют: сыворотку, холестерин,
нуклеиновые кислоты, углеводы, витамины и различные соли.
На плотных средах на
5-7 сутки образуют мелкие колонии – «яичница глазунья». На жидких средах дают очень незначительное помутнение или опалесценцию; некоторые – тончайшую жирную пленку. Чаще всего рост наблюдается у стенок и на дне сосуда.
Для первичного выделения также пригодны куриные эмбрионы и культуры клеток.
Слайд 25Особенности культивирования спирохет
Спирохеты хемоорганотрофы, среди них есть аэробные, факультативно анаэробные
и облигатно анаэробные бактерии.
Treponema pallidum – чрезвычайно прихотлива и
практически не растет на искусственных питательных средах.Боррелии – строгие анаэробы, растут при температуре 20-37 0С (оптимум 28-30 0С) на средах, дополненных животными белками, и на куриных эмбрионах. 2-3 нед.
Лептоспиры – хемоорганотрофы, строгие анаэробы, растут при 28-30 0С, рН 7,2-7,4 на жидких и полужидких средах с добавлением сыворотки кролика, рост наблюдается на 5-8 сут инкубирования (иногда на 21-25 сут).
Слайд 26Особенности физиологии грибков
Грибки – гетеротрофы, аэробы и факультативные анаэробы. Растут
в широких диапазонах температур (оптимальная температура 25-30 0С).
Грибки культивируют
в течение нескольких суток на сусле-агаре или жидком сусле, среде Сабуро, Чапека и др.Слайд 27Особенности физиологии простейших
Простейшие по типу питания могут быть гетеротрофами или
аутотрофами.
Многие простейшие (дизентерийная амеба, лямблии, трихомонады, лейшмании, балантидии) могут
расти на питательных средах, содержащих нативные белки и аминокислоты. Для их культивирования используются также культуры клеток, куриные эмбрионы и лабораторных животных.
Слайд 28Ферменты микроорганизмов
оксидоредуктазы – окислительно-восстановительные ферменты (к ним относятся дегидрогеназы,
оксидазы и др.);
трансферазы, переносящие отдельные радикалы и атомы от одних
соединений к другим;гидролазы, ускоряющие реакции гидролиза, т.е. расщепление веществ на более простые с присоединением молекулы воды (эстеразы, фосфатазы, глюкозидазы и др.);
лиазы, отщепляющие от субстрата химические группы негидролитическим путем (карбоксилазы и др.);
изомеразы, превращающие органические соединения в их изомеры (фосфогексоизомераза и др.);
лигазы, или синтетазы, ускоряющие синтез сложных соединений из более простых (аспарагинсинтетаза, глутаминсинтетаза и др.).
Слайд 29Ферменты микроорганизмов
Эндоферменты и экзоферменты. Внутриклеточные ферменты, объединенные структурно и функционально,
составляют мультиферментные комплексы, например ферменты дыхательной цепи, локализованные на ЦПМ.
Конститутивные
и индуцибельные (адаптивные) ферменты. Ферменты агрессии разрушают ткань и клетки (гиалуронидаза, коллагеназа, ДНКаза, нейраминидаза, лецитовителлаза и др.).
Гликолитические ферменты. Микроорганизмы могут расщеплять углеводы до кислоты или до кислоты и газа. Эти конечные продукты и определяют при помощи дифференциально-диагностических сред.
Протеолитические ферменты бактерий определяют по разжижению желатина и продуктам разложения белка (аминокислот) – индола, сероводорода, аммиака.
Слайд 30Методы выделения чистых культур бактерий
Посев в среду накопления.
Посев на
плотную среду для выделения чистой культуры одним из методов:
посев петлей
штрихом;посев по Дригальскому;
посев различных серийных разведений.
Слайд 31Методы выделения чистых культур бактерий
Пересев изолированной колонии на скошенный агар
(чистая культура).
Слайд 32Методы выделения чистых культур бактерий
Изучение морфологических, тинкториальных, культуральных свойств чистой
культуры.
Пересев чистой культуры на дифференциально-диагностические среды для изучения биохимических свойств.
Определение
других свойств (антигенных, вирулентных), чувствительности к бактериофагам.Определение чувствительности к антибиотикам.